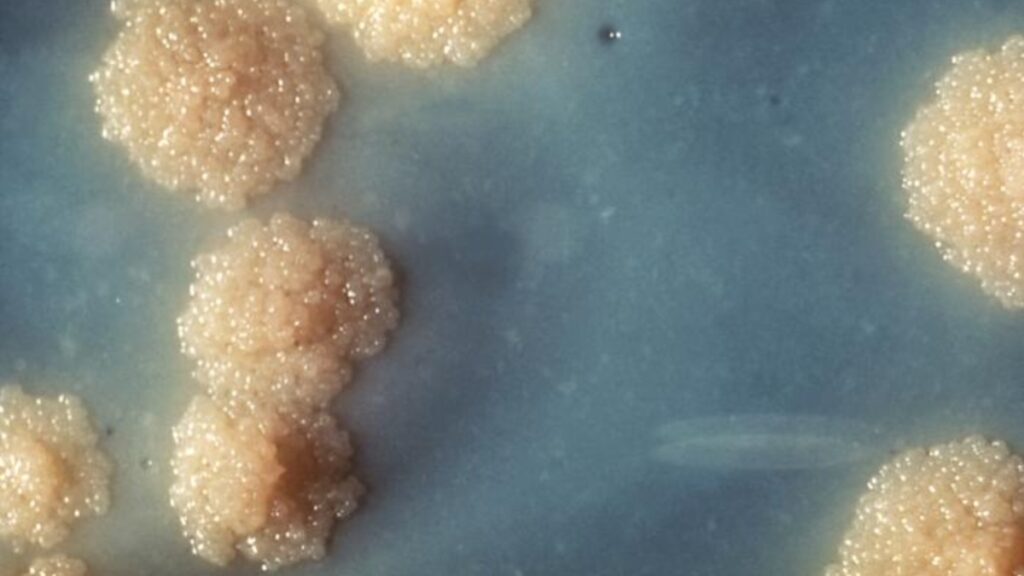
Tuberculosis is rising in the United States, warn experts

Tuberculosis, the deadliest infectious disease in the world, is making a comeback in the United States. Experts point out that school outbreaks, delayed diagnoses, and shortcomings in public health systems are signs that this disease is far from eliminated.
On Tuesday, Vox reported on a tuberculosis outbreak at Archbishop Riordan High School in San Francisco, which has become one of the most notable recent examples of the disease returning to the U.S.
The outbreak began last fall when a student visited a doctor for a persistent cough. However, it took two months to diagnose the student with tuberculosis. Investigators later found a high rate of latent tuberculosis within the school community. As of February 24, four people had confirmed active tuberculosis, and public health officials suspected three more cases.
This outbreak is not unique; Vox reported that tuberculosis cases have also been reported in other U.S. schools, including those on Long Island and in Seattle. Additionally, a significant outbreak occurred in Kansas two years ago, resulting in 68 active cases, 91 latent infections, and two deaths.
🚨BREAKING: Kansas is experiencing a massive outbreak of tuberculosis, which is now being called the largest one in recorded history.
Due to an order from the Trump Administration to restrict and freeze information coming from any and all Health and Human Services Agencies, the… pic.twitter.com/m3w0u4RTqV
— Really American 🇺🇸 (@ReallyAmerican1) January 27, 2025
Globally, tuberculosis continues to be a major killer. The World Health Organization announced that in 2023, tuberculosis became the leading cause of death from a single infectious agent, exceeding COVID-19. About 10.8 million people fell ill, and 1.25 million died worldwide.
In the U.S., the Centers for Disease Control and Prevention has also noted a recent rise. The agency recorded 10,347 tuberculosis cases in 2024, up from 9,633 in 2023. This increase continues the upward trend seen after the pandemic.
The CDC estimates that about 13 million people in the United States carry latent tuberculosis infection, meaning they have the bacteria without showing symptoms or being contagious. Some of these cases can progress to active disease.
Prosecutors say Jose Medina, who is accused of killing a Loyola University student, missed his first court appearance Monday because he has been hospitalized and is undergoing treatment for tuberculosis.
Medina is facing several charges in the fatal shooting, including… pic.twitter.com/HOoQ5ZNwW3
— CBS Mornings (@CBSMornings) March 24, 2026
Vox reported that more than 80 percent of tuberculosis cases in the U.S. originate from latent infections becoming active. Public health researcher RC Sadoff explained that dormant infections can remain in the body for years and may become active when the immune system weakens. “The powder keg is already everywhere,” Sadoff said.
Tuberculosis spreads through the air, and experts noted that it can be hard to detect early because its symptoms often resemble those of other conditions. Priya Shete, an associate professor of medicine at the University of California, San Francisco, stated that tuberculosis “gets diagnosed as everything but tuberculosis.” She added that more vigilance is needed to identify it.
The report indicated that delays in diagnosis during the COVID-19 pandemic, medication shortages, and long-term underfunding of public health infrastructure have all contributed to the problem. Vox also reported that tuberculosis spreads more easily in overcrowded settings and areas with limited access to care, such as prisons and homeless shelters.
While tuberculosis is preventable and curable, health experts emphasized that controlling it requires early testing, consistent treatment, and ongoing funding.
Recent outbreaks and rising case numbers indicate that tuberculosis remains a serious public health threat in the United States, despite the lack of attention paid to the condition.
Health officials say that the risk of general community transmission in the US is still low. But any further slashing of US public health funds and research may lower the ability to keep the incidence of this disease relatively low.